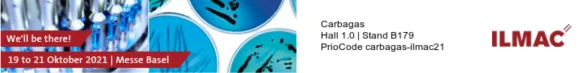
Carbagas Tickets ILMAC

Venez rencontrer nos experts en solutions pour le laboratoire et la pharmaceutique qui vous feront découvrir nos gaz et nos équipements spécialement adaptés à vos besoins.
À découvrir :
- Nos solutions: récipients cryogéniques avec la présence exceptionnelle de représentants de la filiale Cryopal spécialisée dans les équipements cryogéniques pour la Pharma, les labos, et le médical.
- Nos nouvelles solutions: traitement des eaux spécifique résultant du partenariat entre Air Liquide et Inopsys, société spécialisée dans le traitement et la valorisation d'effluents de l’industrie pharmaceutique/chimique.
- Nos équipements pour laboratoire: Station d’inversion compacte SGA, détendeurs gaz haute pureté ...
- Nos équipements gaz dédiés à la pharma: Station d’inversion / détente CISA, module pour connexion sur réseau
- Notre application E-data pour obtenir en 1 clic les certificats d’analyses et fiches de sécurité de vos mélanges de gaz
Nous nous réjouissons de votre visite sur le stand B179, Halle 1, les 19, 20 et 21 octobre à la Messe Basel